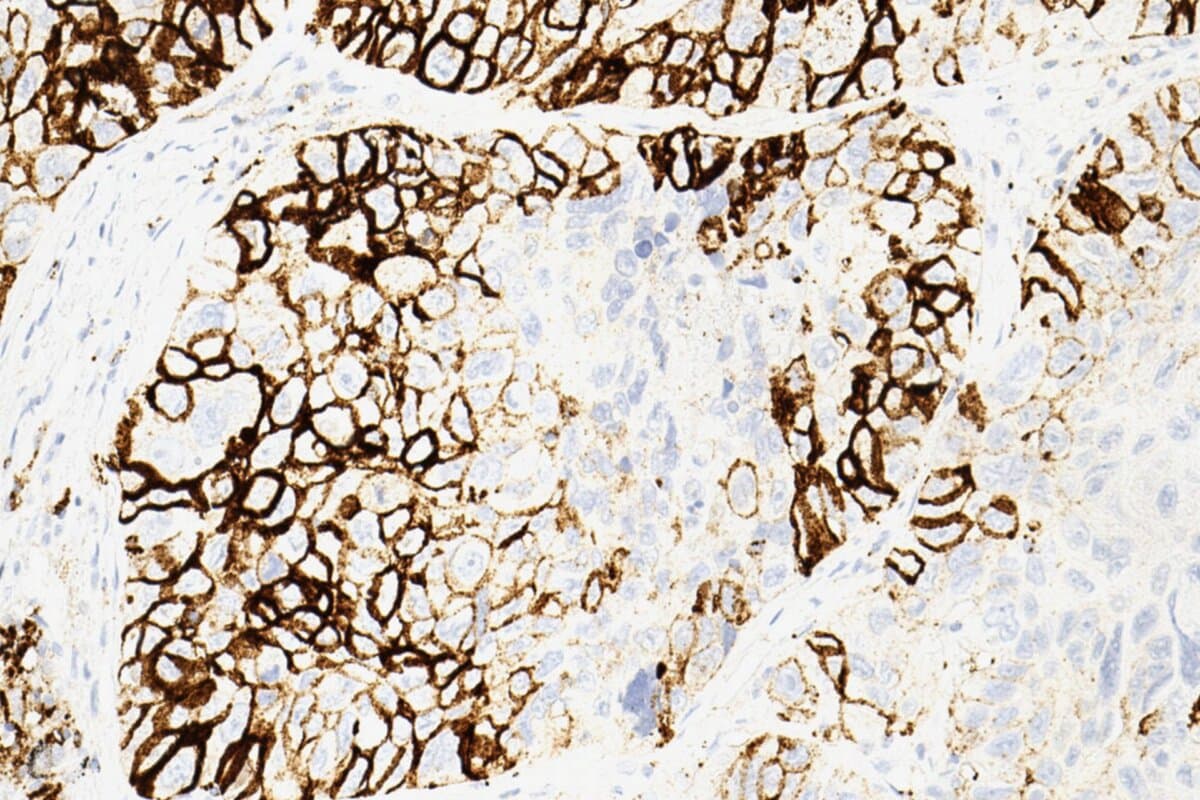

Wer profitiert von einer Immuntherapie?
Ein französisches Forscherteam hat eine vielversprechende Methode zur Präzisierung der Immuntherapie bei metastasierendem nicht-kleinzelligem Lungenkrebs (NSCLC) entwickelt. Der Ansatz basierend auf multimodalen Biomarkern könnte Ärzten und Patienten künftig Therapieentscheidungen erleichtern.
In der Studie im Fachjournal Nature Communications verwendeten die Forscher eine künstliche Intelligenz, um Kombinationen aus klinischen, pathologischen, radiologischen und genetischen Daten zu prüfen. Einige Kombinationen konnten die Erfolgswahrscheinlichkeit einer Immuntherapie deutlich besser vorhersagen als wie bisher einzeln eingesetzte Biomarker wie PD-L1 (1).
Nicht alle NSCLC-Patienten sprechen gleich gut auf Immuntherapien an
Die Immuntherapie mit gegen die Moleküle PD-1 und PD-L1 gerichteten Checkpoint-Inhibitoren kann die Prognose von vielen Patienten mit fortgeschrittenen nichtkleinzelligen Lungenkarzinomen (NSCLC) deutlich verbessern. Doch nicht jeder Betroffene spricht gleich gut auf die Immuntherapeutika an.
Biomarker wie PD-L1 können die Treffgenauigkeit der Immuntherapie zwar bedingt vorhersagen. Studien zeigen jedoch, dass selbst unter Patienten mit hoher PD-1-Expression (≥50 %) nur rund 45 bis 60 Prozent tatsächlich auf eine Immuntherapie ansprechen. Gleichzeitig profitieren rund zehn bis 20 Prozent der Patienten mit niedriger (<1% ) oder nicht nachweisbarer PD-L1-Expression dennoch von einer Immuntherapie. Die PD-L1-Expression stellt daher allein keine zuverlässige Entscheidungsgrundlage für oder gegen eine Immuntherapie dar.
Um die Patientenselektion zu verbessern, werden präzisere Biomarker und Vorhersagemodelle daher dringend benötigt, schreiben die Autoren der vorliegenden Studie.
Künstliche Intelligenz kombiniert mehrere Biomarker für Immuntherapie
Die Forscher untersuchten eine retrospektive Kohorte von 317 Patienten mit metastasierendem NSCLC, die am Institut Curie betreut wurden und eine Erstlinien-Immuntherapie mit Pembrolizumab erhielten.
Von den Teilnehmenden wurden vier zentrale Datensätze gesammelt:
- klinische Parameter wie Alter, Geschlecht und Vorerkrankungen,
- radiologische Bilder aus PET/CT-Scans,
- digitalisierten Gewebeproben aus pathologischen Untersuchungen und
- genetische Profile auf Basis von RNA-Sequenzierungen.
Mithilfe von maschinellen Lernverfahren kombinierte das Team die verfügbaren Informationen zu mehreren unterschiedlichen Scoring-Systemen, die sie etablierten Biomarkern wie PD-L1, der Tumor Mutational Burden (TMB) oder Tumor-infiltrierende Lymphozyten (TILs) gegenüberstellten.
Besonders vielversprechend war die Kombination aus klinischen Daten und RNA-Profilen, die signifikante Prognosevorteile bot. So liess sich die Wahrscheinlichkeit des Einjahres-Überlebens mit einer Präzision von 81 Prozent vorhersagen – ein klarer Fortschritt gegenüber bisherigen Modellen.
Als besonders relevant für eine gute Wirksamkeit von Immuntherapeutika stellten sich RNA-Daten heraus, die auf das reichliche Vorhandensein dendritischer Zellen schliessen lassen.
Therapieentscheidungen gezielter treffen
Die Autoren betonen, dass ihr Konzept den Weg für multimodale Biomarker für personalisierte Therapieentscheidungen ebnen könnte. Um die Praxistauglichkeit und Reproduzierbarkeit zu bestätigen, fordern sie weitere grössere und prospektiv durchgeführte Studien.
Denn bei der vorliegenden Studie handelt es sich um eine retrospektive Analyse mit einer vergleichsweise kleinen Patientenkohorte. Die Aussagekraft der Modelle wurde etwa nur mittels Daten von 80 Patienten überprüft, für die ein vollständiger Datensatz vorlag.
Einige der von den Forschern geprüften Analysen, darunter die vielversprechende RNA-Sequenzierung, werden ausserdem klinisch routinemässig noch nicht durchgeführt, und können eine methodische Herausforderung darstellen.
- Captier N et al. Integration of clinical, pathological, radiological, and transcriptomic data improves prediction for first-line immunotherapy outcome in metastatic non-small cell lung cancer. Nat Commun. 2025 Jan 12;16(1):614. doi: 10.1038/s41467-025-55847-5.